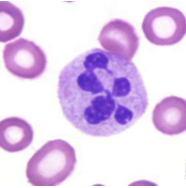
<p>Key Cells of the immune system: Neutrophils</p>
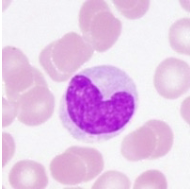
<p>Key Cells of the immune system: Monocytes and Macrophages</p>
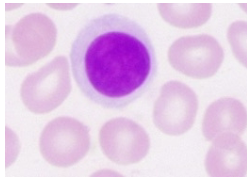
<p>Key Cells of the immune system: Lymphocytes and plasma cells</p>

1/22
Looks like no tags are added yet.
Name | Mastery | Learn | Test | Matching | Spaced | Call with Kai |
|---|
No analytics yet
Send a link to your students to track their progress
Plasma Proteins: Albumin
Source: Liver
Function: Major Contributors to colloid osmotic pressure of plasma; carriers for various substances
Plasma Proteins: Globulins
Source: Liver and lymphoid tissue
Function: Clotting factors, enzymes, antibodies, carriers for various substances
Plasma Proteins: Fibrinogen
Source: Liver
Function: Forms fibrin threads essential to blood clotting
Plasma Proteins: Transferrin
Source: Liver & Other Tissues
Function: Iron transport

Key Cells of the immune system: Basophils and Mast cells
% of WBC’s in blood: Rare
Subtypes and nicknames: None
Primary functions: Release chemicals that mediate inflammation and allergic responses
Basophils specific:
-release histamine
-Inflammation
Classifications: Granulocytes
Key Cells of the immune system: Neutrophils
% of WBC’s in blood: 50-70%
Subtypes and nicknames: Called “polys” or “segs”. Immature forms called “bands” or “stabs.”
-ingest bacteria
-release cytokines
Primary functions: Ingest and destroy invaders
Classifications: Granulocytes, phagocytes

Key Cells of the immune system: Eosinophils
% of WBC’s in blood: 1-3%
Subtypes and nicknames: None
Primary functions: Destroy invaders particularly antibody coated parasites
-Allergic Reactions
-Parasitic diseases
Classifications: Cytotoxic cells, granulocytes(morphological), phagocytes
Key Cells of the immune system: Monocytes and Macrophages
% of WBC’s in blood: 1-6%
Subtypes and nicknames: Called the mononuclear phagocyte system
Primary functions: Ingest and destroy invaders, antigen presentation
Monocytes specific:
-Mature to macrophages
-Phagocytic
-APCs
Classifications: Antigen-presenting cells (APC), phagocytosis
Key Cells of the immune system: Lymphocytes and plasma cells
% of WBC’s in blood: 20-30%
Subtypes and nicknames: B lymphocytes Plasma Cells, T lymphocytes, Cytotoxic T cells, Helper T Cells, Natural killer cells
Primary functions: specific responses to invaders, including antibody production
-acquired immunity (lymphocytes)
Classifications: Antigen presenting cells (APC), Cytotoxic cells

Key Cells of the immune system: Dendritic Cells
% of WBC’s in blood: NA
Subtypes and nicknames: Langerhans cells, veiled cells
Primary functions: Recognize pathogens and activate other immune cells by antigen presentation. These guys don’t move, and need cells to activate it.
-Activate lymphocytes
Classifications: Antigen presenting cells (APC)
Composition of Blood
plasma, platelets, red blood cells, white blood cells
Steps in an immune system response
Detect and ID invader/foreign cells
Communicate, alarm, and recruit immune cells
Coordinate response among all participants
Suppress or destroy invader
Steps in an immune system response: cytokine signaling
How it works:
•A helper T cell (essential white blood cells that coordinate the body’s response to infections) releases IL-2 (Interleukine-2: a critical signaling cytokine that acts as a growth factor for T and B lymphocytes, essential for immune system homeostasis, activation, and tolerance) after recognizing an antigen from an APC (Antigen Presenting Cell).
•That same T cell expresses IL-2 receptors.
•Antigen-activated T cells produce IL-2 themselves, creating a positive feedback loop.
•IL-2 binds back to its own receptors, stimulating intracellular pathways (JAK-SAT, MAPK/Erk an Pi3K/Akt) promoting proliferation, differentiation and survival.
Antigen Presentation Cells involved:
APCs such as a macrophage (a large phagocytic cell found stationary in tissues, or as mobile white blood cells. Especially at sites of infection) phagocytizes a foreign antigen (any substance that is foreign). The antigen is broken down into peptides
Antigen Presentation Key Communication:
APC presents antigen on MHC molecules → recognized by T cell receptor (TCR) → activates T cells.
Type: Contact dependent.
Inflammatory Response: Roles and Players: General
Attract immune cells and chemical mediators to site of infection
Produce physical barrier to prevent infection from spreading
Promote tissue repair
Inflammatory Response: Roles and Players: Histamines from mast cells
Swelling, edema, vasodilation (widening of blood vessels caused by the relaxation of smooth muscle in vessel walls, increases blood flow and lowers blood pressure)
Inflammatory Response: Roles and Players: Interleukins
Fever, blood vessels more permeable to white blood cells
and proteins, acute-phase proteins
Inflammatory Response: Roles and Players: Bradykinin
Pain and swelling
Inflammatory Response: Roles and Players: Complement cascade
Membrane attack complex
Histamine Release and Action
•Mast cells release histamine into the local tissue.
•Histamine diffuses a short distance and binds to histamine receptors (H1, H2, H3, H4) on nearby target cells.
•Effects:
•Blood vessels dilate (vasodilation) → increased blood flow → redness and warmth.
•Capillary permeability increases → fluid leaks out → swelling (edema).
•Smooth muscle contraction in airways or gut → constriction.
•Immune cell recruitment → more white blood cells drawn to the site of infection or allergy.
What does the Neuro-Endocrine-Immune Interaction look like?
It looks like this

Granulocytes
Produced by the bone marrow into 3 different types of WBCs. (neutrophils, eosinophils, and basophils). These guys produced granules that they release to destroy pathogens.
High counts of this in the blood indicate the presence of pathogens, infection, or leukemia.